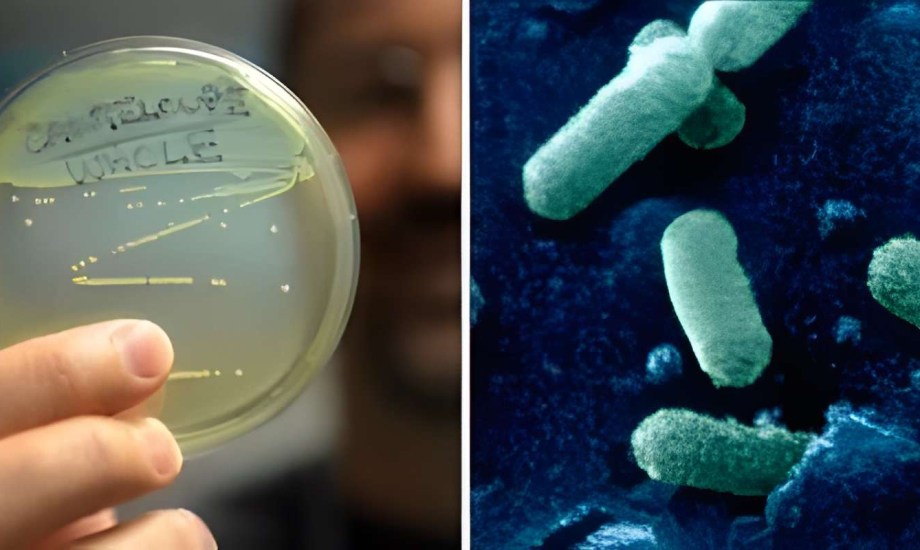
أسباب تفشي الليستيريا في أمريكا

وفاة 9 أشخاص في أمريكا بسبب تفشي الليستيريا
ارتفعت حصيلة الوفيات جراء تفشي الليستيريا المرتبط بمنتجات Boar’s Head إلى 9 أشخاص، في وقت يعد فيه هذا التفشي من أكبر حالات الإصابة منذ تفشي مرض الليستيريا المرتبط بفاكهة الكنتالوب في عام 2011، والذي أسفر عن وفاة 33 شخصاً.
تفاصيل التفشي
 آلم العضلات من أعراض مرض الليستيريا
آلم العضلات من أعراض مرض الليستيريا
وفقاً للتحديث الأخير من مركز السيطرة على الأمراض والوقاية منها (CDC)، نُقل 57 شخصاً إلى المستشفى منذ مايو بسبب هذا التفشي، الذي طال 18 ولاية أمريكية من بينها أريزونا وفلوريدا وجورجيا وإلينوي وماريلاند ونيويورك ونيوجيرسي، كان العدد الأكبر من الإصابات في ولاية نيويورك، حيث سجلت 17 حالة، تليها ولاية ماريلاند بـ8 إصابات، ونيوجيرسي بـ5 إصابات.
بدأت الأعراض تظهر على أحد المصابين في منتصف أغسطس الماضي، ما يبرز التحذير بأن عدوى الليستيريا قد تستغرق ما يصل إلى 10 أسابيع لتظهر، تشمل الأعراض الشائعة الحمى وآلام العضلات والإرهاق، إضافةً إلى صداع وتصلب الرقبة والارتباك وفقدان التوازن أو حتى نوبات تشنجية.
تحذيرات من CDC وإجراءات وقائية
شدد مركز السيطرة على الأمراض (CDC) على أهمية فحص الثلاجات والتأكد من خلوها من المنتجات المتأثرة مع ضرورة تنظيف أي مكان تم تخزين المنتجات فيه أو استخدامها لأن الليستيريا "جرثومة قوية ومقاومة"، وكانت وزارة الزراعة الأمريكية قد أصدرت استدعاء على مستوى البلاد لبعض منتجات كبد اللحم liverwurst من Boar’s Head التي تم تقطيعها في أقسام الأطعمة الجاهزة.
 الوقاية من مرض الليستيريا
الوقاية من مرض الليستيريا
تفاصيل المنتجات المستدعاة
بعد فحص معملي من السلطات الصحية في ولاية ماريلاند، تم اكتشاف بكتيريا Listeria monocytogenes في عبوة مغلقة من liverwurst، حالياً تشمل قائمة المنتجات المستدعاة التي نشرتها Boar’s Head نحو 57 منتجاً تتضمن البولوبيف واللحم المقدد والنقانق والسجق، كما تضم المنتجات المتأثرة الأصناف التي تم تقطيعها طازجة في أقسام الأطعمة الجاهزة أو المعبأة مسبقاً، وتم تحديث قائمة المنتجات المتأثرة، ما يتيح للمستهلكين الاطلاع على التفاصيل بشكل مستمر.